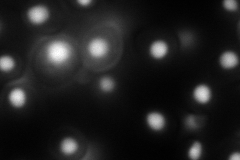
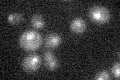

View description
Conserved zinc-finger domain protein involved in pre-mRNA splicing, required for assembly of U4 snRNA into the U4/U6 particle
Localization:
Intensity:
Fold change:
Significance:
-
C’ GFP library in SD

nucleus18.48 -
N' NOP1pr-GFP in SD

nucleus77.2577 -
N' TEF2pr-mCherry in SD
nucleus137.244 -
N' NATIVEpr-GFP in SD

nucleus27.7624 -
N' TEF2pr-VC and Cyto-VN in SD

nucleus44.0983 -
C’ GFP library in SD+DTT

nucleus19.511.05No -
C’ GFP library in SD+H2O2

nucleus21.971.18No -
C’ GFP library in Starvation Media
nucleus15.80.85No -
C’ GFP library on the background of Pup2-DaMP

nucleus -
C’ GFP library on the background of CCT mutant

nucleus19.26361.04197No
